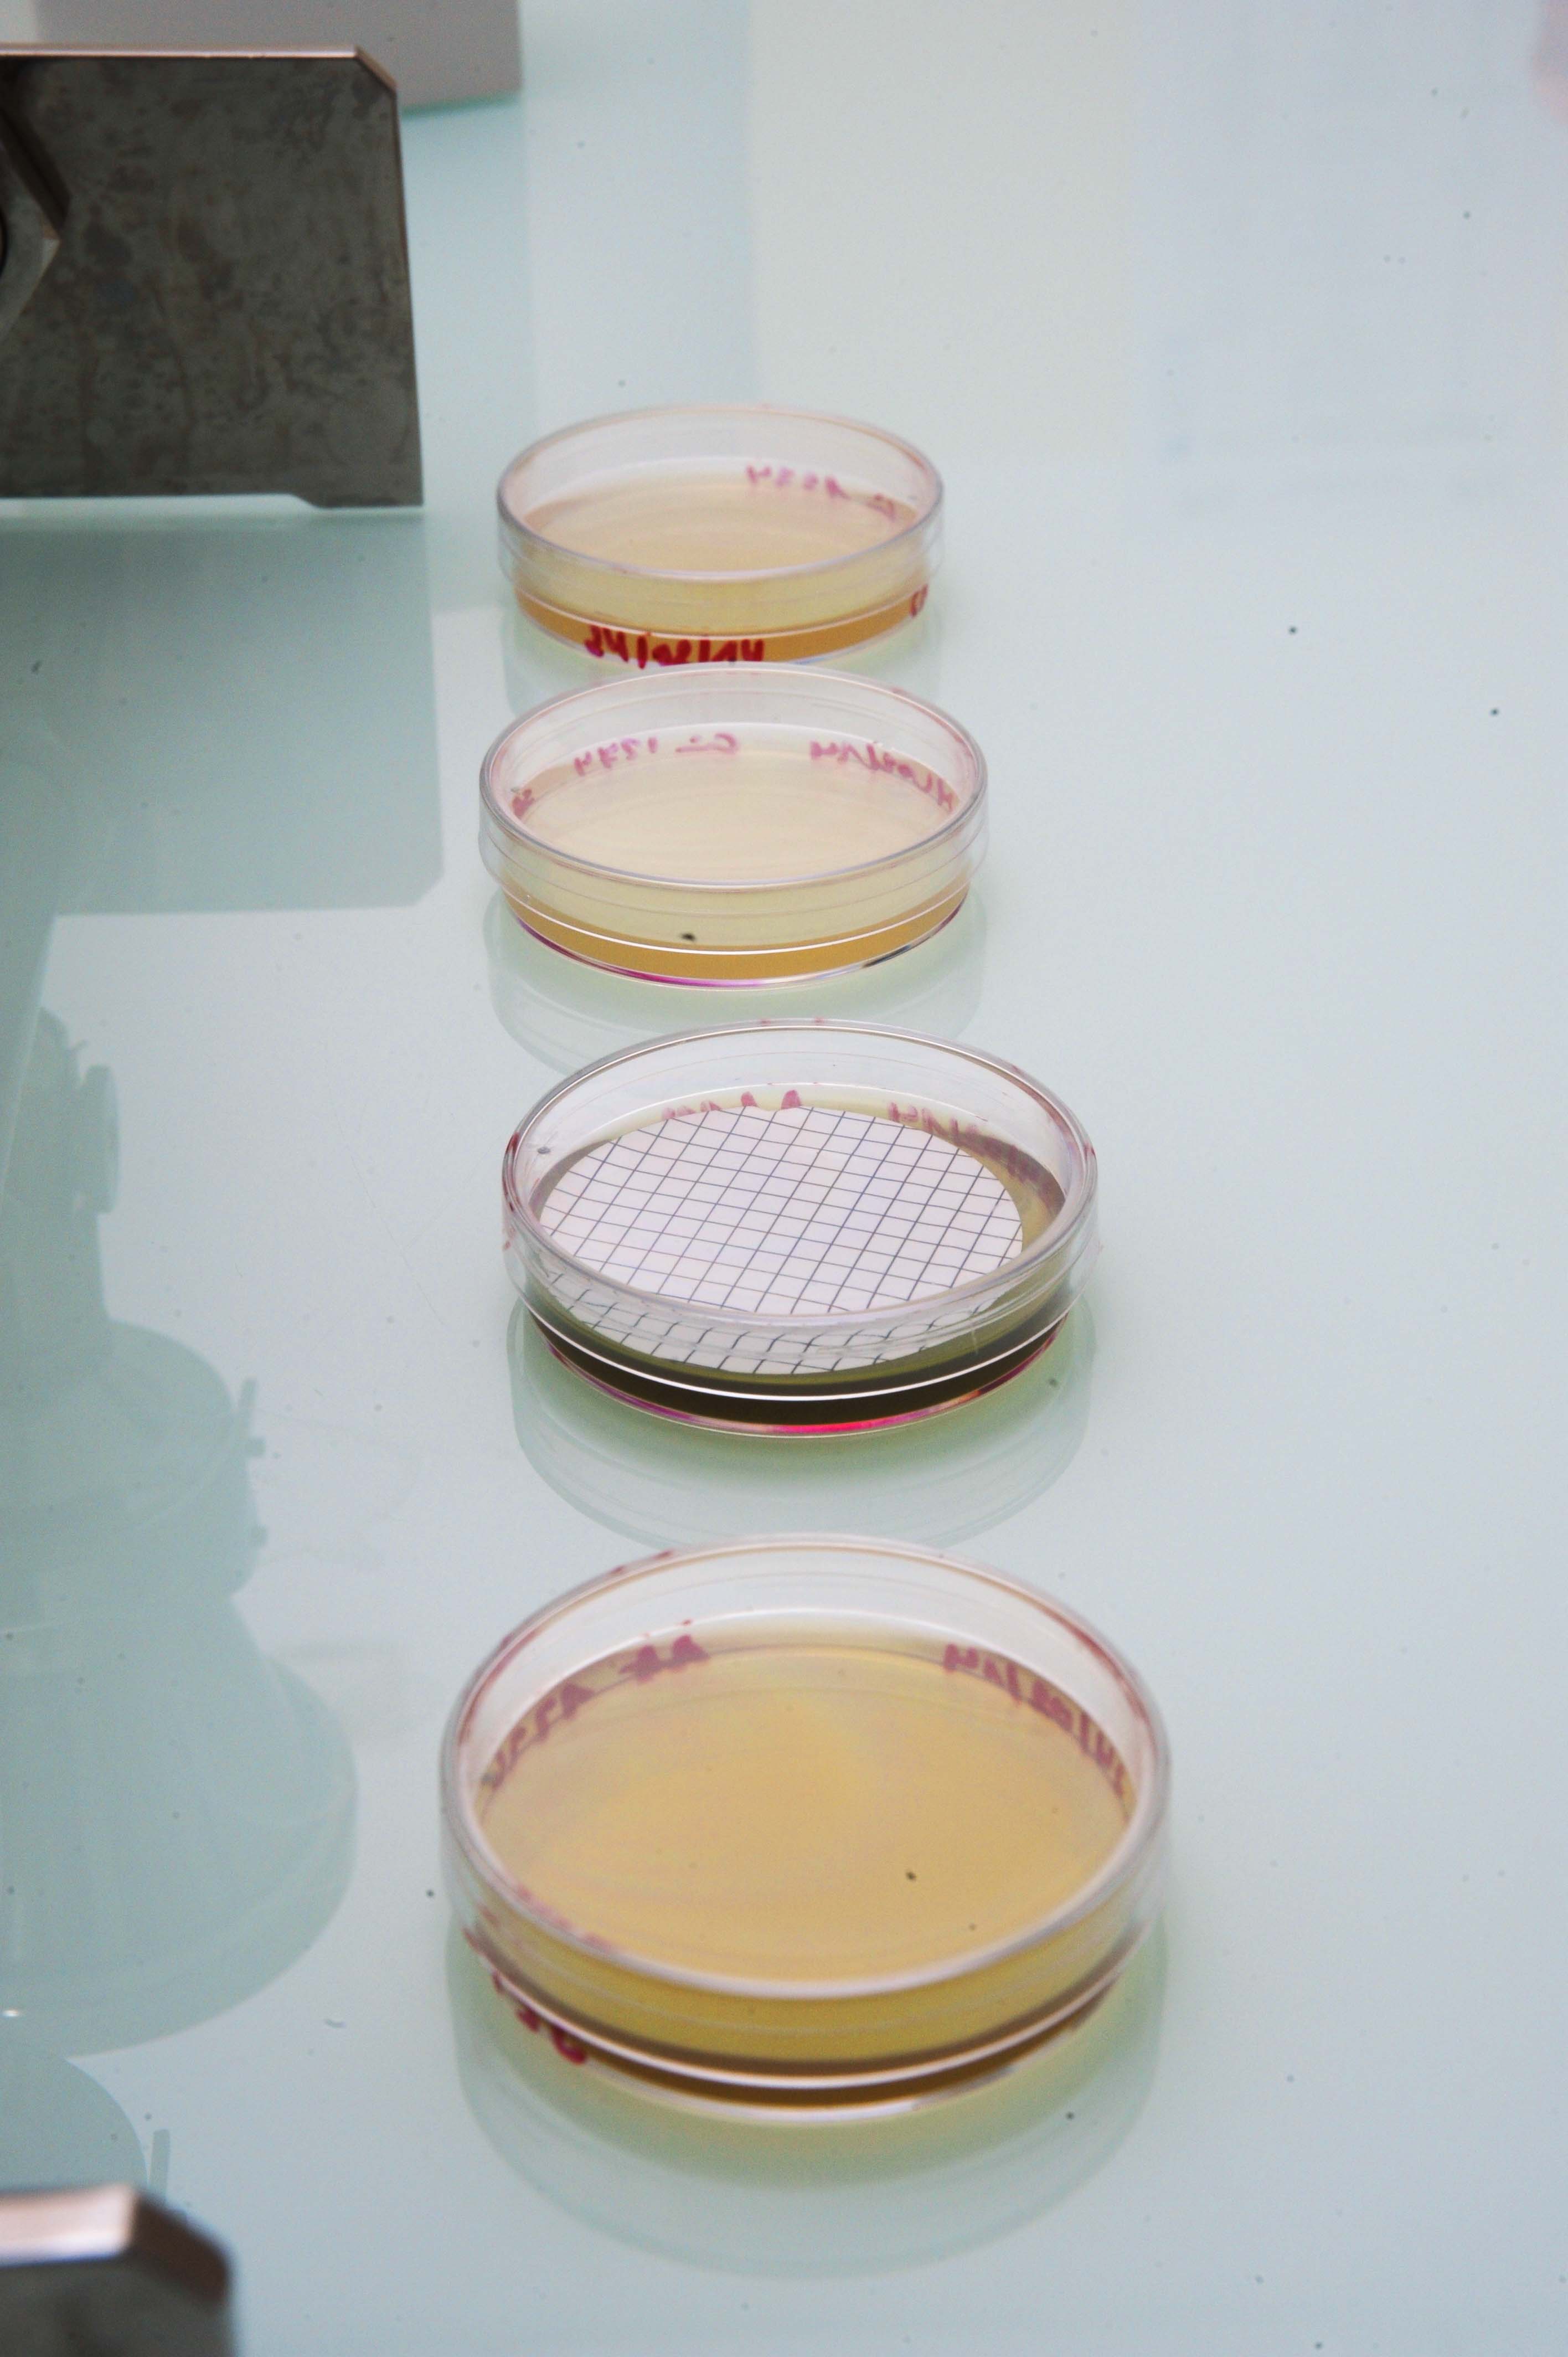
Qualité Agro-alimentaire

L'Excellence
Analytique
Garantir la sécurité sanitaire et la qualité de votre chaîne alimentaire avec des technologies de pointe et une expertise reconnue.

Garantir la sécurité sanitaire et la qualité de votre chaîne alimentaire avec des technologies de pointe et une expertise reconnue.
Un accompagnement sur mesure pour tous les acteurs de la filière agro-alimentaire.
Surveillance aux frontières pour assurer la conformité sanitaire des produits importés.
DécouvrirAnalyses microbiologiques et physico-chimiques accréditées et fiables.
DécouvrirProgrammes annuels de surveillance de la chaîne bioalimentaire.
DécouvrirMontée en compétence de vos équipes sur les normes d'hygiène internationales.
Découvrir"Le LANAA renforce son assise qualité pour mieux assurer la sécurité alimentaire des Djiboutiens. Face aux enjeux sanitaires mondiaux, nous sommes le rempart de confiance."Lire le mot du Directeur


Afin d'acquérir des notions théoriques et pratiques essentielles, nous proposons des modules de formation adaptés à votre secteur d'activité, directement en entreprise ou dans nos locaux modernes.
Catalogue de FormationContrôler toute importation des denrées alimentaires au niveau des ports, aéroports et barrières d'importations pour assurer la sécurité sanitaire dès l'entrée sur le territoire.

Garantir la qualité des produits dans les restaurants, hôtels et hôpitaux. Surveiller les produits mis sur les marchés nationaux destinés à la consommation humaine et animale.

Lancer des plans de surveillance visant les produits de la chaîne bioalimentaire afin d'assurer la salubrité des aliments offerts à la consommation sur le territoire Djiboutien.

Effectuer des programmes de formation ainsi que des expertises en matière de normes HACCP pour accompagner les professionnels du secteur.

21 35 80 67
contact@lanaa.dj
Port de pêche, Djibouti